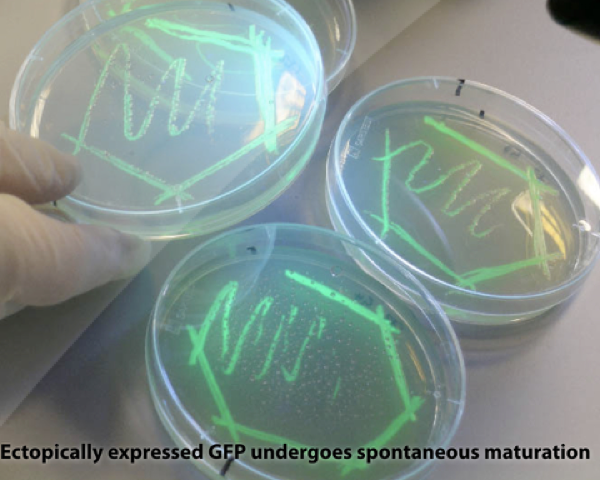
collage image title

-

Lecture2a_2019.001
-

Lecture2a_2019.002
-

Lecture2a_2019.003
-

Lecture2a_2019.004
-

Lecture2a_2019.005
-

Lecture2a_2019.006
-

Lecture2a_2019.007
-

Lecture2a_2019.008
-

Lecture2a_2019.009
-

Lecture2a_2019.010
-

Lecture2a_2019.011
-

Lecture2a_2019.012
-

Lecture2a_2019.013
-

Lecture2a_2019.014
-

Lecture2a_2019.015
-

Lecture2a_2019.016
-

Lecture2a_2019.017
-

Lecture2a_2019.018
-

Lecture2a_2019.019
-

Lecture2a_2019.020
-

Lecture2a_2019.021
-

Lecture2a_2019.022
-

Lecture2a_2019.023
-

Lecture2a_2019.024
-

Lecture2a_2019.025
-

Lecture2a_2019.026
-

Lecture2a_2019.027
-

Lecture2a_2019.028
-

Lecture2a_2019.029
-

Lecture2a_2019.030
-

Lecture2a_2019.031
-

Lecture2a_2019.032
-

Lecture2a_2019.033
-

Lecture2a_2019.034
-

Lecture2a_2019.035
-

Lecture2a_2019.036
-
Lecture2a_2019.037
-

Lecture2a_2019.038
-

Lecture2a_2019.039
-

Lecture2a_2019.040
-

Lecture2a_2019.041
-

Lecture2a_2019.042
-

Lecture2a_2019.043
-

Lecture2a_2019.044
-

Lecture2a_2019.045
-

Lecture2a_2019.046
-

Lecture2a_2019.047
-

Lecture2a_2019.048
-

Lecture2a_2019.049
-

Lecture2a_2019.050
-

Lecture2a_2019.051
-

Lecture2a_2019.052
-

Lecture2a_2019.053
-

Lecture2a_2019.054
-

Lecture2a_2019.055
-

Lecture2a_2019.056
-

Lecture2a_2019.057
-

Lecture2a_2019.058
-

Lecture2a_2019.059
-

Lecture2a_2019.060
-

Lecture2a_2019.061
-

Lecture2a_2019.064